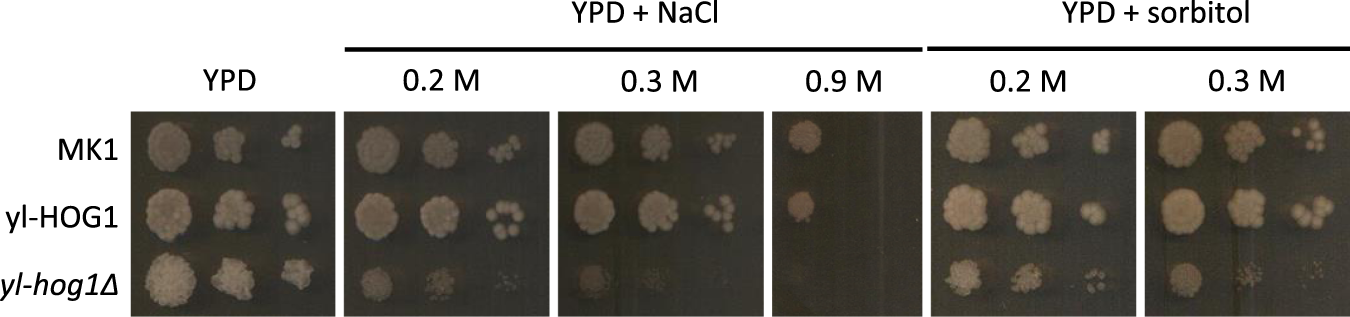
Figure 2

Figure 2
From: Influence of ylHog1 MAPK kinase on Yarrowia lipolytica stress response and erythritol production
Growth of Y. lipolytica strains MK1, yl-hog1Δ and yl-HOG1 after 48 h on YPD agar medium supplemented with different concentrations of NaCl or sorbitol.
